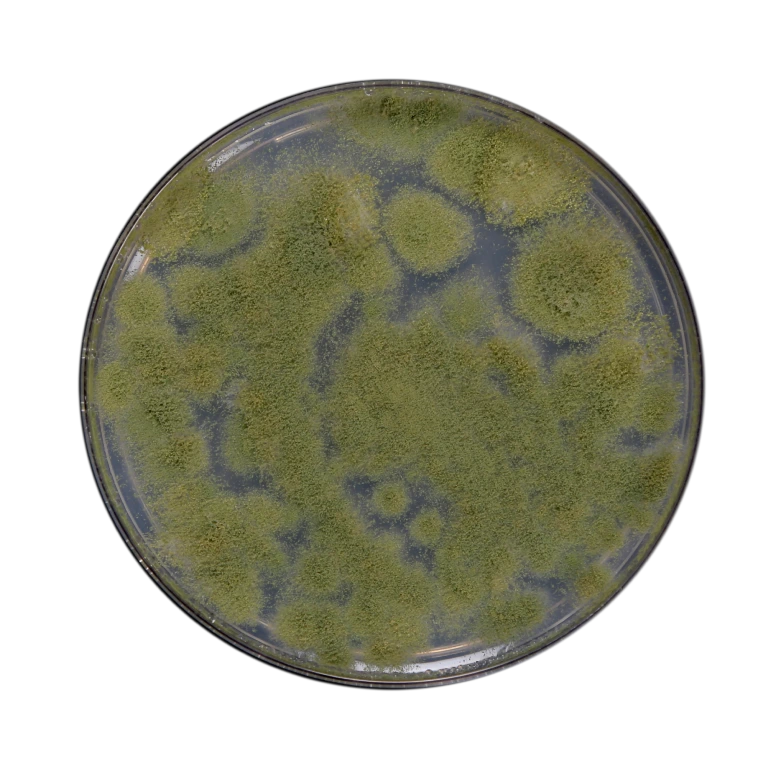
product

Talc Base Bio Pesticide Powder
Trichoderma Viride
Trichoderma viride is a highly effective organic biocontrol agent that…
Learn More


Metarhizium Anisopliae
Metarhizium species (Metschnikoff) Sorokin, commonly referred to as green muscardine…
Learn More
Nematodes Free
The nematophagous fungus Pochonia chlamydosporia var. chlamydosporia is among the…
Learn More
Pseudomonas
Fluorescent Pseudomonads are part of the Plant Growth Promoting Rhizobacteria…
Learn More

Bacillus thuringiensis kurstaki (BTK)
Bacillus thuringiensis kurstaki (BTK) is a strain of Bacillus thuringiensis…
Learn More
Bacillus thuringiensis israelensis (BTI)
Bacillus thuringiensis Israelensis (BTI) is a strain of Bacillus thuringiensis…
Learn More
Bacillus Subtilis
Bacillus subtilis is a natural biofungicide and Plant Growth-Promoting Rhizobacteria…
Learn More